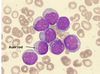

CBL_7 Haematology Flashcards
Normal hematopoiesis diagram

What’s the most preferred location for bone marrow biopsy?
upper pelvic bone (posterior iliac crest) -> no major blood vessels or organs are located nearby

Do malignant cells function normally?
No
Why we can see abnormal blood count in leukemia?
Leukaemia cells proliferating in the bone marrow will replace normal cells -> reduce other elements of the bone marrow -> abnormal blood counts
*as bone ,arrow will become ‘over-crowded’
What type of leukemia is more common in old age?
Acute Myeloid Leukemia (AML)
What type of leukemia is more common in children?
Acute Lymphoblastic Leukemia (ALL)
What’s the Philadelphia chromosome?
Chromosome 22
*in chronic myeloid leukemia: arms of chromosomes 22 and 9 switches the places (translocation)
This combination causes BCR-ABL genes to combine -> this switches Tyrosine Kinase -> uncontrolled proliferation

(2) characteristics of myelodysplastic syndrome
- defective maturation of myeloid cells
- build up of blasts (in the bone marrow)
What % of blasts is seen in:
A. Myelodysplastic syndrome
B. ALL

Risk factors for Acute Leukemia
- Down Syndrome
- exposure to radiotherapy (e.g. used in Rx for other malignancy)
- exposure to alkylating chemotherapy
Symptoms of AML and ALL

Why is there hepatosplenomegaly and lymphadenopathy in leukemia?
Blasts (T cells) migrate to the organs
What does peripheral blood smear show in AML and what in ALL? (simply)

Features of myeloblasts in leukemia on peripheral blood smear
myeloblasts in leukemia = AML

Features of lymphoblasts in leukemia on peripheral blood smear
Lymphoblasts = ALL

What are (2) markers for lymphoblastic leukemia in immunophenotyping ?
- CD10 -> surface marker for pre B cells
- TdT -> DNA polymerase only in lymphoblasts
What is the key distinction between Acute and Chronic Leukemias?
Acute -> cells do not mature at all
Chronic -> cells mature only partially
What is a simple difference in pathophysiology of CML and CLL?
- CML -> cells divide too quickly
- CLL -> cells do not die as they should
Result of both: too many premature cells (as chronic leukemia = cells develop only partially)
Symptoms of Chronic Myeloid and Chronic Lymphoid Leukemia

The difference on a peripheral blood smear in CML and CLL

Clinical features of Acute Leukemias
–Tiredness, infection, bruising/bleeding
–High white cell count
–Low haemoglobin (anaemia)
–Low platelet count (thrombocytopenia)
–Low neutrophil count (neutropenia)
What type of cancer is it?
Auer Rod = Acute Myeloid Leukemia
What’s therapy for AML? (2)
AML
–3 to 4 cycles of combination chemotherapy
–Haemopoietic stem-cell transplant (HSCT) for some patients
What’s myelodysplasia?
Myelodysplasia -> an acquired neoplastic disorder of hematopoietic stem cells, they are pre-leukaemia and are most likely to progress to AML
They are more common with age, and they present with bone marrow failure













